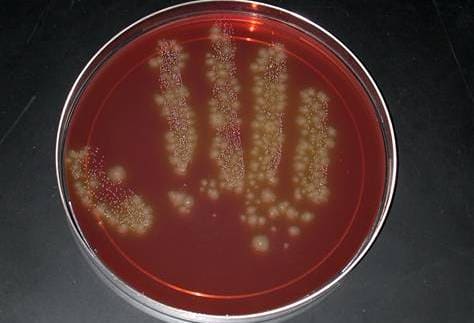
Клостридии при бакпосеве

Клостридии – это достаточно обширная группа микроорганизмов, представители которой являются не только причиной незначительного нарушения здоровья, но и серьезных инфекций, одно только упоминание о которых вызывает тревогу – это столбняк, ботулизм, газовая гангрена. Причем специфическая профилактика, а именно вакцинация, разработана только при столбняке, тогда как остальные болезни, вызванные клостридиями, могут поражать различные слои населения, встречаясь преимущественно в виде спорадических случаев.

Клостридии
Описание клостридий
Клостридии (Clostridium) – это грамположительные микроорганизмы (при окраске по Грамму приобретают сине-фиолетовый цвет), относящиеся к семейству Clostridiacae, роду Clostridium. Первое описание клостридий датировано 1880 годом польским ученым микробиологом А. Пражмовским. Представляют собой палочки размером от 0,5 до 20 мкм, подвижные, обладают различной протеолитической активностью (способностью вырабатывать ферменты) в зависимости от вида. Способны образовывать споры, в результате которых приобретают форму «веретена» в связи с тем, что раздуваются в центре за счет образования эндоспоры (именно от греческого слова «веретено» и произошло их название). Особенность образовывать эндоспоры позволяет клостридиям выдерживать кипячение и быть малодоступными для антибиотиков. Иногда эндоспоры располагаются терминально, что придает клостридиям форму «теннисных ракеток». Клостридии являются анаэробами (размножаются при отсутствие кислорода).
К роду Clostridium относятся 100 и более видов бактерий. Наиболее известные из них C. botulinum (возбудитель ботулизма), C. tetani (возбудитель столбняка), C. septicum, C. perfringens, C. oedematiens, C. novyi (возбудители газовой гангрены), C. difficile, C. hystoliticum, C. sporogenes, C. clostridioforme, C. acetobutylicum, C. colicanis, C. aerotolerans, C. bifermentans, C. tertium, C. piliforme, C. laramie, C. ramosum, C. fallax, C. formicaceticum и другие.
Клостридии широко распространены в природе, могут обнаруживаться в почве, в водоемах. Некоторые клостридии (например, C. difficile) являются представителями нормальной микрофлоры некоторых систем организма человека, то есть являются сапрофитами. Чаще всего они обнаруживаются в кишечнике, на коже, слизистой оболочке ротовой полости, женской половой системы, респираторного тракта. Но все же основное место обитания – кишечник. В норме у совершенно здоровых людей количество клостридий зависит от возраста и составляет: у детей до 1 года – до 103 КОЕ/г (колониеобразующих единиц в грамме фекалий), у детей с 1 года и взрослых до 60 лет – до 105 КОЕ/г, старше 60 лет – до 106 КОЕ/г. C. difficile нередко высевают из почвы и воды, в которых, благодаря образованию эндоспор, она может сохраняться до 2х и более месяцев.
Факторы патогенности клостридий
Особенность клостридий и заболеваний, вызванных ими, это выработка токсинов и симптомы, связанные с ними, то есть клостридиозы - токсикоинфекции.
1) Токсинообразование – это фактор патогенности клостридий. Некоторые виды клостридий (C. botulinum, C. tetani, C. perfringens) продуцируют одни из самых сильных бактериальных экзотоксинов (ботулотоксин, столбнячный токсин – тетаноспазмин, ε-токсин, разрушающий эритроциты). Экзотоксины обладают нейротоксичностью (действие на нервную систему), гемотоксичностью (на эритроциты и лейкоциты), некротоксичностью (вызывает некроз тканей).
2) Другим фактором патогенности является инвазивность – способность локального повреждения тканей за счет выработки ряда протеолитических ферментов. В частности, C. perfringens способна вырабатывать протеиназу (расщепляющую белки), коллагеназу, гиалуронидазу. Такие факторы агрессии, как протеиназа, лецитиназа, гиалуронидаза, коллагеназа, являются результатом жизнедеятельности многих видов клостридий.
Главной особенностью патогенного действия клостридий является преобладание некротических процессов в тканях над воспалительными, выраженность которых минимальна. Итак, жизнедеятельность клостридий осуществляется в анаэробных (без кислорода) условиях и сопровождается выработкой токсинов, ферментов и белков, который определяют газообразование и некроз в тканях, а также общее токсическое влияние на организм больного (чаще это нейротоксическое влияние).
Общие причины заражения инфекциями, вызванными клостридиями
Источником инфекции может быть больной и носитель как человек, так и животное, с испражнениями которого клостридии попадают в почву, на дно водоемов, где могут сохраняться несколько месяцев. Механизмы заражения – алиментарный (пищевой), контактно-бытовой. В зависимости от вида клостридий и симптомов болезни заражение здорового человека происходит через определенные факторы передачи. Факторами передачи пищевого пути служат пищевые продукты (мясные продукты, фрукты и овощи, молоко и молочные продукты), для ряда болезней, как ботулизм например, это продукты с созданием анаэробных условий без предварительной термической обработки (консервы, соления, копчености, вяленые продукты, колбасы домашнего приготовления). Контактно-бытовой механизм реализуется через раневой путь инфицирования, когда споры клостридий определенных видов попадают на поврежденные кожные покровы. Также описаны случаи болезней новорожденных (в условиях нарушения правил стерильности), что бывает при столбняке, ботулизме и других клостридиозах.
Заболевания, вызванные клостридиями
Ботулизм (С. botulinum)
Столбняк (С. tetani)
Газовая гангрена (С.perfringens тип А, С.septicum, C.oedematiens, C.novyi)
Псевдомембранозный колит (C.difficile, С.perfringens тип А)
Антибиотикоассоциированные диареи (C.difficile)
Некротический энтерит, пищевая токсикоинфекция (С.perfringens тип А)
Ботулизм (возбудитель С. botulinum) – острое инфекционное заболевание, характеризующееся поражением нервной системы с развитием парезов и параличей гладкой и поперечнополосатой мускулатуры. Главная особенность возбудителя – способность вырабатывать один из сильнейших микробиологических ядов – ботулотоксин, который и запускает развитие всех симптомов болезни. Более подробно по поводу данного заболевания в статье «Ботулизм».
Столбняк (возбудитель С. tetani) – также острая инфекционная болезнь с поражением нервной системы и тоническим сокращением мышц поперечнополосатой группы. Данный возбудитель также имеет отличительную особенность – выработку сильного токсина – столбнячного экзотоксина, обуславливающего тяжелую клинику заболевания. Подробнее о столбняке в статье «Столбняк».
Газовая гангрена (возбудители С.perfringens тип А, С.septicum, C.oedematiens, C.novyi) – инфекция, которая развивается в анаэробных условиях при активном участии некоторых видов клостридий, которая развивается на обширных участках поврежденных тканей. Развивается после обширных ранений, травм, травматических ампутаций, огнестрельных ранений. Сроки появления газовой гангрены – первые 2-3 дня с момента ранения или другой тяжелой травмы. В очаге инфекции клостридии находят благоприятные условия для размножения (отсутствие кислорода, омертвевшие клетки и ткани), выделяют токсины, вызывая интоксикацию всего организма и возможное поражение токсинами других органов и систем. У пациента в местном очаге наблюдается отек тканей, газообразование, омертвление тканей, распространение процесса на здоровые участки. Выделяют несколько форм – классическая, отечно-токсическая, гнилостная и флегмонозная. Помощь пациенту нужно оказывать как можно скорее, иначе распространение процесса может стоить больному жизни.

Газовая гангрена
Псевдомембранозный колит или ПМК (вызывается чаще C.difficile, но может играть роль и С.perfringens тип А). ПМК также развивается вследствие антибиотикотерапии, частыми виновниками которой являются линкомицин, ампициллин, тетрациклин, левомицетин, клиндамицин, реже цефалоспорины. Следствием такого лечения является грубый дисбактериоз кишечника с выраженной активностью одного из рассматриваемых нами микробов - C.difficile. Жизнедеятельность клостридии вызывает воспаление слизистой оболочки кишечника, в основном дистального его отдела, образованием так называемых «псевдомембран» - фибринозных налетов на слизистой оболочке. Такие нарушения грозят развитием осложнения – прободения стенки кишечника, что может привести к летальному исходу. Группы риска по развитию ПМК: лица преклонного возраста (старше 65 лет), а также лица с сопутствующими заболеваниями (онкология, пациенты после оперативных вмешательств и другие). У пациента развивается температура и интоксикация (слабость, головная боль), однако эти симптомы необязательны. Также характерно расстройство стула, который становится частым, водянистым. У ослабленных пациентов могут возникнуть симптомы обезвоживания. Стул может напоминать изменения при холере (водянистый беловатого цвета, частый и обильный), однако в тяжелых случаях при сильном болевом синдроме может появиться стул с примесью крови.

Эндоскопическая картина ПМК
Антибиотикоассоциированные диареи или ААД (вызываются C.difficile, С.perfringens), однако может быть микробная ассоциация с грибами рода Candida, клебсиеллой, стафилококком и другими. Чаще регистрируются в условиях лечебных учреждений среди пациентов, требующих антибиотикотерапии в силу того или иного заболевания. Именно в этих условиях и формируются устойчивые к лекарственным препаратам виды клостридий. Наблюдаются чаще при назначении препаратов широкого спектра (цефалоспорины, ампициллин и других). Возникают антибиотикоассоциированные диареи за счет сочетанного подавления роста как патогенной, так и сапрофитной (вполне нормальной) микрофлоры пищеварительной системы человека. Риск возникновения такой диареи не связан напрямую с количеством антибиотика в организме (она может возникнуть и при первом приеме, и при повторных введениях лекарства). Группы риска по развитию ААД – пациенты, принимающие цитостатики и имеющие иммунодефицит.
Симптомами ААД являются высокая температура и интоксикация (слабость, недомогание), появление водянистого стула с патологическими примесями (слизь, иногда кровь), боли в околопупочной области, а затем по всему животу. При заражении C.difficile нередки случаи повторной клиники (рецидива) через 4-6 дней в силу устойчивости спор клостридий к лечению. У детишек первых 3х месяцев, учитывая малую обсемененность кишечника и находящихся на грудном вскармливании ААД возникает редко.
Некротический энтерит (причиной является С.perfringens типа F). Некротоксин клостридии вызывает некроз стенки кишечника и образованием эррозированных поверхностей и язв (то есть разрушение стенки кишечника). В месте поражения наблюдаются воспалительные изменения с отеком слизистой. Есть опасность кровотечения и прободения язвы, а также развития тромбоза мелких сосудов. Пациенты жалуются на температуру, рвоту и жидкий стул с кровью и обилием пены.
Пищевая токсикоинфекция, вызванная С.perfringens длится несколько дней. Клинически мало отличий от токсикоинфекции другой этиологии. Симптомы болезни обусловлены токсином клостридии и появляются через несколько часов (чаще это 6-12 часов) с момента употребления в пищу недоброкачественных продуктов питания ( чаще мясные продукты). Пациенты предъявляют жалобы на жидкий стул, тошноту, редко рвоту, болезненность в животе.
Поражение мочеполовой системы. В некоторых случаях клостридии могут явиться первопричиной развития острого простатита.
Клостридиальный сепсис может развиться при распространении большого количества токсинов по организму и токсического поражения различных органов и систем, в том числе и жизненноважных (почки, головной мозг, печень).
Диагностика клостридиозов
Предварительный диагноз ставится на основании симптомов конкретной клинической картины, связи заболевания с какой-либо обширной травмой, назначением антибиотиков, употреблением в пищу характерных продуктов питания и тому подобное. Диагноз подтверждается после лабораторной и инструментальной диагностики.
Лабораторная диагностика включает в себя:
1) Бактериоскопия первичная материалов для исследования.
2) Бактериологический метод, при котором происходит идентификация возбудителя. Материалом для исследования служит отделяемое из ран, испражнения и другие в зависимости от клинической формы. При сепсисе это может быть кровь, моча. Материал засевают на селективные питательные среды (например, среда Кита-Тароцци) и выращивают в анаэробных условиях.
Клостридии при бакпосеве
3) Биологическая проба для выявления токсинов клостридий, с целью которой применяется реакция нейтрализации специфическими антитоксическими сыворотками.
4) Параклинические методы исследования (общий анализ крови, мочи, копрограмма, биохимические исследования крови).
5) Инструментальная диагностика. При рентгенологическом исследовании можно обнаружить скопление газа в подкожном пространстве и мышечной ткани, что наведен на предварительные выводы о клостридиях (газ можно обнаружить и при других анаэробных инфекциях). При ПМК проводят эндоскопическое исследование, при котором видна картина очагового или диффузного (распространенного) колита с образованием псевдомембран.

clostridium difficile под микроскопом
Лечение клостридиозов
Пациенты с клостридиозными инфекциями подлежат госпитализации по показаниям и тяжести.
Такие заболевания, как ботулизм, столбняк, газовая гангрена лечатся только в стационаре и требуют немедленной помощи с целью спасения жизни пациента. Некоторые виды диарей являются госпитальными, поэтому также лечатся в стационаре.
Медикаментозная помощь включает в себя:
1) Введение специфических препаратов с целью нейтрализации токсинов при ботулизме (противоботулиническая сыворотка, иммуноглобулин) и столбняке (противостолбнячная сыворотка, иммуноглобулин). Эти препараты подлежат тщательному расчету и постановке строго под наблюдением врача в больнице. Сыворотки чужеродные, поэтому должна быть готовность к возможному проведению противошоковых мероприятий.
2) Антибактериальная терапия, с целью которой назначаются антибиотики, к которым клостридии имеют чувствительность. К ним относятся: нифуроксазид, метронидазол, рифаксимин, тинидазол, доксициклин, тетрациклин, клиндамицин, кларитромицин, пенициллин, левофлоксацин. Выбор препарата остается только за лечащим доктором, который заподозрил и подтвердил диагноз определенной клинической формы клостридиозной инфекции. Для лечения антибиотикассоциированных поражений кишечника лекарственный препарат, вызвавший данное состояние, отменяют. Для этиотропной терапии может быть рекомендован ванкомицин для приема внутрь, метронидазол.
3) Хирургический метод лечения (актуален при газовой гангрене) и сводится к иссечению поврежденных участков раны с последующей антибактериальной санацией.
4) Симптоматическое лечение в зависимости от клинического синдрома (это могут быть пробиотики, уросептики, гепатопротекторы, жаропонижающие, противовоспалительные и другие группы препаратов).
Профилактика клостридиозов
Одно из важных правил – тщательное соблюдение правил личной гигиены в домашних условиях и в социальной среде: обработка рук после туалета, тщательная обработка продуктов питания, в том числе и термическая. Профилактические меры относятся и к медицинским работникам: контроль и динамическое наблюдение за назначением антибактериальных препаратов, особенно ослабленным пациентам отделений реанимации, онкогематологических стационаров, реципиентам органов и тканей.
Врач инфекционист Быкова Н.И.




Комментарии